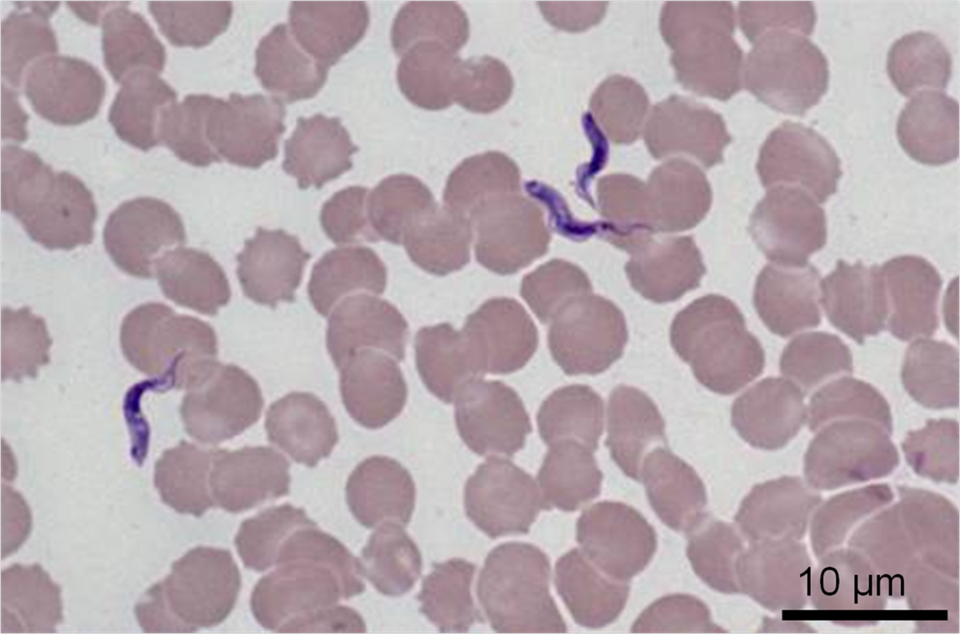

Trypanosoma congolense in Hundeblut (Jack-Yves Deschamps, Marc Desquesnes, Laetitia Dorso, Sophie Ravel, Géraldine Bossard, Morgane Charbonneau, Annabelle Garand and Françoise A. Roux)
Trypanosoma congolense in Hundeblut (Jack-Yves Deschamps, Marc Desquesnes, Laetitia Dorso, Sophie Ravel, Géraldine Bossard, Morgane Charbonneau, Annabelle Garand and Françoise A. Roux)